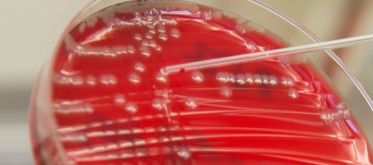
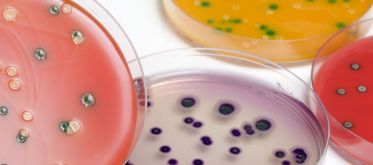

Les infections, intoxications et maladies d'origine alimentaire
Consommer un aliment contaminé peut entraîner des infections ou intoxications d’origine alimentaire, causées par des bactéries, virus ou parasites. Si ces maladies sont souvent bénignes, elles peuvent parfois avoir des conséquences graves, notamment chez les populations sensibles comme les enfants, les femmes enceintes ou les personnes âgées. Ce dossier vous aide à comprendre les principaux risques, les aliments concernés et les bons gestes à adopter pour se protéger au quotidien. Il met aussi en lumière le rôle de l'Anses dans la prévention et la surveillance de ces dangers.